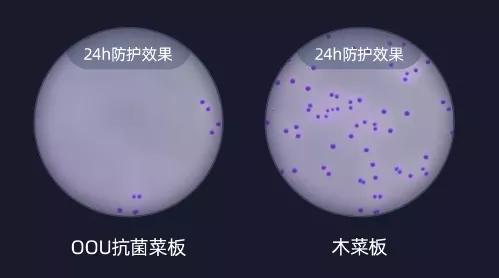
日本科技挑战中国传统！99元砧板连角落都有用，网友：服气

一块用上好几年的木砧板,总逃不过下面这种命运......

老话说“病从口入”,根据数据显示,在中国90%以上的人都患有不同程度的肠胃疾病,而这就和我们的不良饮食习惯息息相关。

如何做到健康饮食呢?除了把关入口的美味,还要保证厨房用品的干净整洁,要知道,厨房中很多用品都会直接接触食材,比如锅、刀具、以及砧板。

大家喜欢用木砧板,因为它密度高、韧性强、使用起来很牢固。但它也有缺点,长时间使用表面容易产生刀痕,清洁不彻底的话,很容易藏污纳垢,滋生细菌,污染食物。

相较于木砧板而言,竹子砧板使用起来更安全些,但它的密度不及木砧板,且厚度不够,多为拼接而成,因此使用时不能重击。

塑料砧板,也在厨房占有一席之地,它重量轻携带方便。正因如此,它很容易变形,而且一些质地粗糙的塑料菜板,很容易切出渣沫,随食物进入人体,影响身体健康。

以上砧板,好处坏处参半,实在太苦恼!是时候献出我们的“秘籍”了!厨房黑科技——OOU抗菌砧板了解一下?

它采用了日本黑科技,在长效抑菌的同时也不伤刀,另外还有多种设计,帮你解决基础问题的同时,带来不一样的新奇体验。
有了它,让你爱上厨房!

日本进口材料,99%抗菌不发霉
该砧板采用了具有弹性韧性很好的TPR材料和环保材质麦香料加工制成,高密度韧性好不伤刀防霉也抗菌,也不容易藏污纳垢。
经过了SGS的严格实验检测,不仅可以抑制99%的细菌滋生,而且砧板软硬适中, 一点也不伤刀。

菜板用完后洗不干净,还容易串味?

还不赶紧来一块OOU抗菌砧板,轻松一擦就超干净,洗起来也方便,而且一点残留都没有。


耐热100℃不变形,一手拎起轻松收纳
塑料菜板一烫就变形?PP材质的OOU抗菌砧板,能耐100℃高温,不变形也不会滋生细菌。

砧板爱滑动切什么都白费,而OOU抗菌砧板的边缘采用了一种无毒无味的高分子环保材质TPR制成,相较于传统菜板而言,韧性更好,也更加柔软防滑。

一块好的砧板,太轻太重都不行!而OOU抗菌砧板重量恰好合适,一手就能轻松拎起来。

再看下厚度,跟1角硬币差不多。

大小也合适,挂起来或者直立在墙面都可以,一点也不占地。

“多功能”砧板,质量上乘颜值高
你敢想吗?OOU抗菌砧板还能磨刀!任何大刀小刀只需从侧面插入,单向抽拉即可,磨完的刀又亮又快,还不容易生锈。

有了它,让你从此爱上“磨刀霍霍向猪羊”的感觉。

此外,OOU抗菌菜板还附带了打泥功能,可以打蒜泥、姜末,还能弄各种宝宝吃的蔬菜泥,水果泥,并且研磨出来的泥非常细腻。



不仅正面能用,把砧板转个面也照样还能用。
超高颜值的它,能当做果盘使用,摆在桌上美观大方。

凹槽设计可以做杯垫,轻松沥水,让桌子保持干净!


OOU抗菌砧板不仅质量上乘,还深获欧盟美国等30多个国家和地区的认可!

目前仅售价99元/件,两种颜色任君挑选:仿大理石色/小麦色。

如何花更少的钱来守护全家人的健康?其实,你只是少了一块OOU抗菌砧板。

OOU多功能防霉菜板
¥99
购买
#科技好物大赏# #618好物趋势#